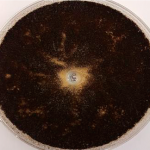
Petrischale mit Standard-Tiefgrund - großer Pilzbefall der Probe ist zu sehen
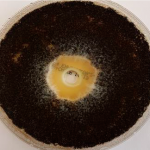
Petrischale mit Wettbewerbs-Tiefgrund mit fungzider Ausrüstung - mittelgroßer Pilzbefall der Probe ist zu sehen
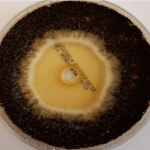
Petrischale mit hawo FungGrund 2in1 - nur geringer Pilzbefall der Probe ist zu sehen

FungiGrund 2in1 – Wirkungsweise bestätigt
Mit Algen oder Pilzen befallene Flächen müssen vor der Überarbeitung mit Farben oder Putzen desinfiziert werden. Oft ist zusätzlich zur Regulierung der Untergrund-Saugfähigkeit und zur Untergrundverfestigung eine Tiefengrundierung notwendig.
Der hawo FungiGrund 2 in 1 vereinigt beide Funktionen und spart somit einen Arbeitsgang! Eine unabhängige Untersuchung im Labor bestätigt diese Wirkungsweise.
Die hervorragende Wirkungsweise dieser innovativen Tiefengrundierung wurde durch das Mikrobiologische Labor Dr. Michael Lohmeyer GmbH mittels Hemmhoftest untersucht und bestätigt. Im Labortest verglichen wurden 2 Tiefengrundierungen ohne zusätzliche fungizide Ausrüstung, 1 Wettbewerbsprodukt mit fungizider Ausstattung und der hawo FungiGrund 2 in 1. Das weitaus beste Testergebnis konnte hier der neue FungGrund 2 in 1 erzielen.
Dieses Ergebnis zeigt anschaulich, dass der FungiGrund 2 in 1 erheblich mehr Sicherheit bei der Vorbehandlung von befallenen Flächen bei gleichzeitiger Tiefengrundierung bietet.
Für einen langfristigen Schutz vor erneutem Befall, ist bei der Außenanwendung immer eine anschließende Beschichtung mit Filmkonservierung zu empfehlen.